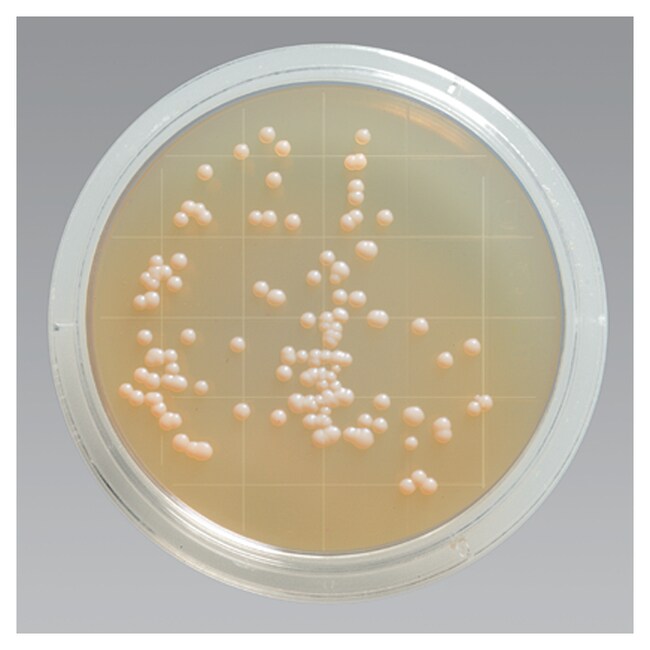
Remel&trade; 无菌接触皿胰蛋白酶大豆琼脂（含卵磷脂、聚山梨醇酯 80，经辐照）
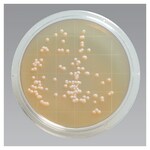
Remel&trade; 无菌接触皿胰蛋白酶大豆琼脂（含卵磷脂、聚山梨醇酯 80，经辐照）
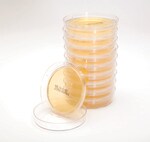
Remel&trade; 无菌接触皿胰蛋白酶大豆琼脂（含卵磷脂、聚山梨醇酯 80，经辐照）

Search
Thermo Scientific™
Remel™ 无菌接触皿胰蛋白酶大豆琼脂(含卵磷脂、聚山梨醇酯 80,经辐照)
Thermo Scientific™ Remel 无菌接触皿胰蛋白酶大豆琼脂(含卵磷脂、聚山梨醇酯 80,经辐照)用于培养细菌、酵母菌和真菌。
| 货号 | 数量 |
|---|---|
| R111800 | 10 支/包 |
货号 R111800
价格(CNY)
-
数量:
10 支/包
Thermo Scientific™ Remel 无菌接触皿胰蛋白酶大豆琼脂(含卵磷脂、聚山梨醇酯 80,经辐照)用于培养细菌、酵母菌和真菌。
- 双层袋外加第三层袋的密封形式提供客户使用(双层 + 外袋)
- 产品在洁净室环境下生产,经过 γ 辐照保证无菌
- 采用 GripFit™ 技术制成,确保皿盖在搬动过程中保持不动,而在环境监测时又可轻松移除
不适用于 IVD 用途。
规格
描述接触皿;无菌;胰蛋白酶大豆琼脂(含卵磷脂);γ 辐照
产品规格接触皿—双层袋
数量10 支/包
产品类型琼脂
Unit SizeEach